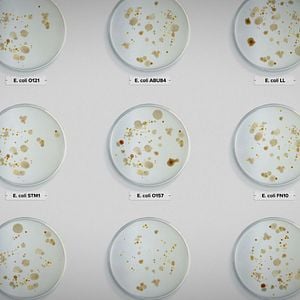
Foto Intoxicación: La cruda verdad de nuestra comida

Este documental de la directora Stephanie Soechtig revela cómo décadas de indiferencia y mala praxis han dejado el suministro de alimentos estadounidense y a los consumidores vulnerables expuestos a patógenos mortales como la E. coli y la salmonela. La película expone cómo las malas prácticas de higiene, los controles inadecuados y el afán de lucro ponen en peligro la seguridad alimentaria en Estados Unidos.

Netflix
Suscripción
Ver todas las ofertas de streaming
 2:02
2:02
Nacionalidad
EE.UU.
Distribuidora
-
Año de producción
2023
Tipo de película
Largometraje
Anécdotas
-
Presupuesto
-
Idiomas
Inglés
Formato de producción
-
Color
Color
Formato audio
-
Formato de proyección
-
N° de Visado
-